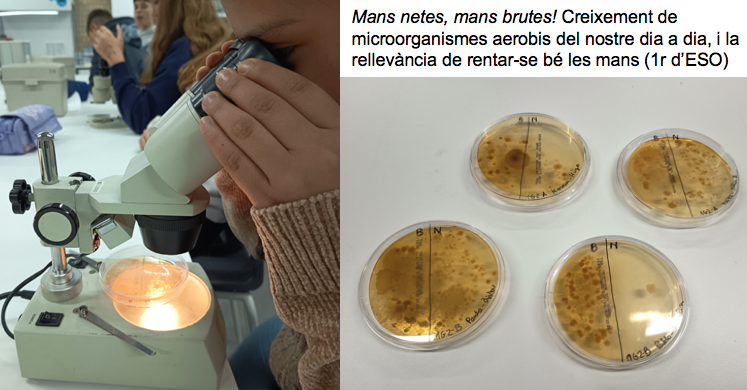
Captura de pantalla 2026-02-14 a las 9.05.53

Departament de Ciències Experimentals A l’ésser humà li encanta sorprendre’s i meravellar-se. Aquesta és la llavor de la ciència. Estudiar la ciència és intentar comprendre tot allò que veiem, i també el que no veiem. La ciència és més que un conjunt de coneixements: és una manera de pensar.
Des de l’Institut Gallecs, apostem per pensar. Per això apostem per la ciència
Les ciències experimentals a l’ESO
Captura de pantalla 2026-04-09 a las 23.32.51
Captura de pantalla 2026-04-09 a las 23.32.35
Captura de pantalla 2026-04-18 a las 10.30.03
Captura de pantalla 2026-02-14 a las 9.26.11
Captura de pantalla 2026-02-14 a las 9.23.02
Captura de pantalla 2026-02-14 a las 9.05.53
Captura de pantalla 2026-02-17 a las 18.52.37
Captura de pantalla 2026-02-15 a las 8.37.44
Captura de pantalla 2026-02-15 a las 8.36.35
Captura de pantalla 2026-02-14 a las 10.05.03
Captura de pantalla 2026-02-14 a las 10.01.46
Captura de pantalla 2026-02-14 a las 9.56.46
Captura de pantalla 2026-02-14 a las 9.54.31
Captura de pantalla 2026-02-14 a las 9.51.04
Captura de pantalla 2026-02-14 a las 9.49.12
Captura de pantalla 2026-02-14 a las 9.47.01
Captura de pantalla 2026-02-14 a las 9.44.11
Captura de pantalla 2026-02-14 a las 9.28.01
El Batxillerat cientĂfic tecnològic
Captura de pantalla 2026-02-08 a las 9.54.49
Captura de pantalla 2026-02-08 a las 10.03.57
Captura de pantalla 2026-02-08 a las 10.16.44
Captura de pantalla 2026-02-08 a las 10.11.14
Captura de pantalla 2026-02-08 a las 10.24.47
Captura de pantalla 2026-02-08 a las 10.27.27
Captura de pantalla 2026-02-08 a las 10.08.00
Captura de pantalla 2026-02-09 a las 22.23.56
Captura de pantalla 2026-02-09 a las 22.26.25
Captura de pantalla 2026-02-09 a las 22.34.16
Captura de pantalla 2026-02-09 a las 22.36.55
Captura de pantalla 2026-02-09 a las 22.29.51
Captura de pantalla 2026-02-09 a las 22.38.52
Captura de pantalla 2026-02-09 a las 22.53.46
Captura de pantalla 2026-02-09 a las 22.58.17
Captura de pantalla 2026-02-09 a las 22.41.22
Captura de pantalla 2026-02-08 a las 10.07.41
Captura de pantalla 2026-02-08 a las 9.47.35
Captura de pantalla 2026-02-08 a las 10.06.11
Projectes i activitats:
Cada curs el departament de ciències experimentals organitza el concurs de fotografia cientĂfica amb l’objectiu de divulgar la ciència. El tema d’enguany era “les flors” i podeu veure tot el recull, amb les respectives descripcions, al vĂdeo que trobareu al web de l’institut. No us el perdeu!
VIDEO
El Departament de Ciències ha creat un canal de podcast  amb l’objectiu de fer divulgaciĂł cientĂfica. Els continguts sĂłn elaborats per l’alumnat del nostre centre.
Enguany, els alumnes i les alumnes de 4t d’ESO que cursen l’assignatura de fĂsica i quĂmica han preparat la primera temporada que tracta temes de quĂmica.